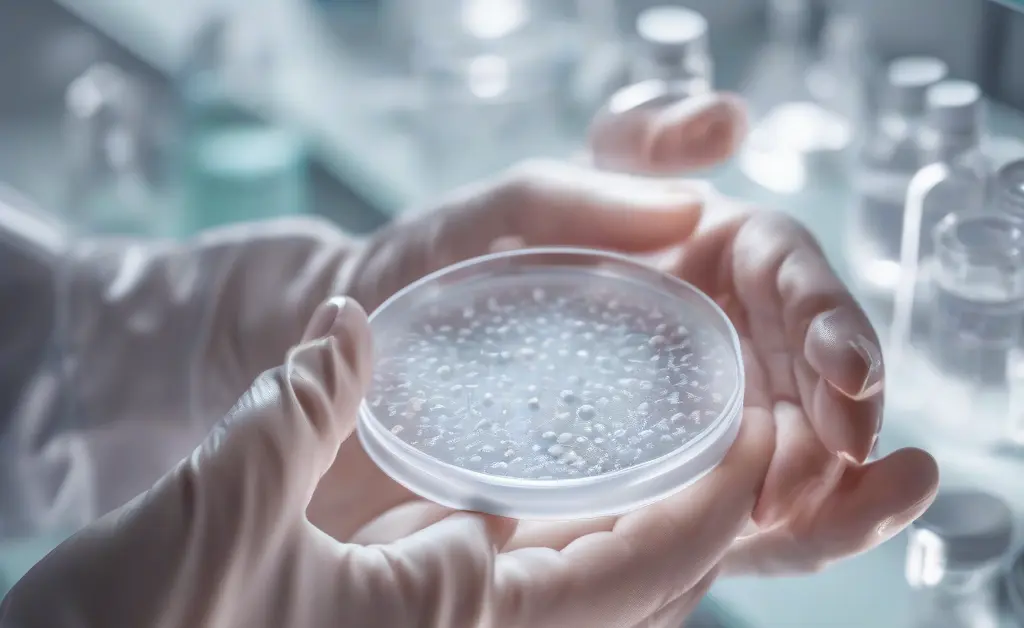

Chaga mushroom benefits for fertility are gaining increasing attention as more individuals look for natural ways to support their reproductive health. Known for its rich concentration of bioactive compounds, chaga mushroom may help promote hormonal balance, support cellular health, and enhance overall wellness, all of which play an important role in fertility. By exploring how chaga mushroom benefits for fertility work within the body, readers can better understand its potential as a natural supplement and how it may contribute to a healthier, more balanced reproductive system.
Introduction to Chaga Mushroom and Fertility
Overview of Chaga Mushroom Properties
Chaga mushroom, scientifically known as Inonotus obliquus, is a parasitic fungus commonly found on birch trees in cold climates. Renowned for its rich composition of antioxidants, polysaccharides, and bioactive phytochemicals, chaga has been traditionally valued for its adaptogenic and immune-supporting qualities. These properties contribute to its reputation as a super-fungus with countless facets, including potential benefits for overall health and reproductive wellness. The mushroom’s ability to modulate oxidative stress and inflammation may play a role in creating a physiological environment conducive to fertility by supporting cellular integrity and hormonal regulation. For more details on the broad health advantages, see chaga mushroom benefits.
Medicinal Mushrooms and Their Role in Fertility

Common Medicinal Mushrooms Used for Fertility
Several medicinal mushrooms have been studied for their effects on reproductive health and fertility. Species such as reishi (Ganoderma lucidum), cordyceps (Cordyceps sinensis), and maitake (Grifola frondosa) are often recognized for their hormone-regulating and immune-enhancing properties. These fungi are believed to act as natural fertility boosters by supporting the endocrine system, reducing oxidative stress, and promoting balance within the reproductive axis. Their adaptogenic effects help the body respond to stress, which is a significant factor influencing fertility outcomes.
Differences Between Chaga and Other Fertility Supplements
While many fertility supplements focus on vitamins, minerals, or hormone precursors, chaga mushroom distinguishes itself through its complex array of phytonutrients and antioxidant compounds. Unlike some supplements that target a single pathway, chaga offers a multifaceted approach by simultaneously supporting immune function, reducing inflammation, and potentially influencing hormone regulation. This broad spectrum of activity may complement other fertility supplements but also requires careful consideration given its potent bioactive profile. Additionally, chaga’s traditional use as a herbal medicine emphasizes holistic wellness rather than isolated reproductive effects. The increasing interest in specific forms like chaga mushroom extract benefits highlights the diverse applications of this fungus.
Chaga Mushroom’s Impact on Female Fertility
Effects of Chaga on Female Reproductive System
The influence of chaga mushroom on the female reproductive system centers around its antioxidant and anti-inflammatory properties, which may help protect ovarian cells from oxidative damage. Oxidative stress is commonly linked to diminished ovarian reserve and impaired egg quality, factors that significantly affect fertility. By mitigating cellular stress and supporting hormonal balance, chaga is thought to contribute to reproductive health. Furthermore, its potential to modulate the endocrine system may assist in regulating menstrual cycles and supporting the hormonal milieu necessary for conception. For those interested in various forms, chaga mushroom powder benefits provide an accessible alternative for supplementation.
How Chaga Mushroom May Influence Fertility Hormones and Cellular Health
Chaga Mushroom and Hormonal Balance
Chaga’s bioactive compounds are under investigation for their role in hormone regulation, particularly concerning sex hormone stimulation and endocrine system support. The adaptogenic nature of chaga suggests it may help harmonize hormone levels by interacting with the hypothalamic-pituitary-gonadal axis, which governs reproductive hormones. While direct effects on hormones such as estrogen and progesterone require further scientific validation, the mushroom’s influence on systemic inflammation and oxidative stress indirectly supports hormonal stability, a critical factor in fertility.
Cellular Health and Fertility Connection
Cellular health is fundamental to reproductive success, as egg and sperm quality depend heavily on the integrity of cellular structures and DNA. Chaga mushroom’s rich antioxidant profile combats oxidative stress, a major disruptor of cellular function and genetic material. By neutralizing free radicals and reducing inflammation, chaga may help maintain the health of reproductive cells and tissues. This protective effect on cellular health aligns with the broader concept of reproductive health antioxidants, which are increasingly recognized as natural fertility boosters. Additionally, chaga is sometimes valued for its chaga mushroom benefits for sleep, which can further support overall wellness.
Scientific Evidence and Research Supporting Chaga Mushroom Benefits for Fertility
Summary of Current Research Findings
Scientific research on chaga mushroom’s direct benefits for fertility remains limited but promising. Studies have highlighted its antioxidant and anti-inflammatory effects, which are foundational to reproductive health. Some research explores chaga’s impact on immune modulation and hormone regulation, suggesting potential pathways through which it may support fertility. However, more targeted clinical trials are necessary to confirm these effects specifically in the context of human fertility. The existing body of evidence underscores chaga’s potential as a complementary natural supplement within fertility support strategies, warranting further exploration. Regulatory considerations are important as well; the FDA provides guidance on supplement safety and standards.
Safe Usage Guidelines and Potential Risks of Chaga Mushroom for Fertility
Precautions When Using Chaga Mushroom
When considering chaga mushroom for fertility support, it is important to approach usage with caution. Variability in preparation methods and supplement quality can affect the concentration of active compounds, making standardized dosing challenging. Individuals with autoimmune conditions or those taking anticoagulant medications should be particularly vigilant, as chaga may influence immune system activity and blood clotting mechanisms. Consulting with a healthcare professional knowledgeable in herbal supplements is advisable to ensure safe integration of chaga into wellness routines.
Potential Side Effects Related to Fertility
While chaga is generally well-tolerated, potential side effects such as allergic reactions or interactions with hormonal therapies may occur. Concerns have been raised regarding liver toxicity in some cases, emphasizing the need for careful monitoring. In the context of fertility, any supplement that affects hormone regulation or immune responses should be used judiciously, as unintended alterations could impact reproductive processes. Awareness of chaga mushroom benefits and side effects helps users make informed decisions and recognize signs that warrant medical attention.
Nutritional Components of Chaga Mushroom Related to Fertility
Key Nutrients in Chaga Supporting Fertility
Chaga mushroom contains a variety of nutrients and bioactive compounds that may contribute to reproductive health. These include polysaccharides, betulinic acid, triterpenoids, and melanin, which collectively exhibit antioxidant and anti-inflammatory properties. The presence of essential minerals and vitamins further supports cellular functions involved in fertility. These nutritional components are integral to chaga’s role as an adaptogen and antioxidant source, helping to create a physiological environment that supports hormone regulation and reproductive cell vitality.
Traditional Uses of Chaga Mushroom in Fertility Practices

Historical Fertility Remedies Involving Chaga
In traditional herbal medicine, particularly within Siberian and Northern European cultures, chaga mushroom has been used as a general tonic to promote vitality and longevity. While not exclusively targeted at fertility, its application often encompassed reproductive health through its systemic strengthening effects. Herbal healers valued chaga for its ability to support the immune system, reduce inflammation, and balance bodily functions, all of which are essential for maintaining reproductive wellness. These historical uses provide context for the contemporary interest in chaga as a natural fertility supplement.
Preparation Methods for Chaga Mushroom
Traditional preparation of chaga mushroom involves slow extraction processes such as decoction or infusion to release its bioactive compounds effectively. Typically, the mushroom is dried, ground, and simmered in water to create a tea or tincture. Modern supplements may use concentrated extracts or powders standardized for specific phytochemicals. Understanding these preparation methods is important for appreciating the potency and bioavailability of chaga’s constituents, which influence its potential impact on fertility and overall health.
In summary, chaga mushroom benefits for fertility are linked to its comprehensive antioxidant properties, immune support, and potential hormone regulatory effects. While traditional use and preliminary scientific research suggest promising roles in reproductive health, careful consideration of safe usage and individual response is essential. Incorporating chaga alongside other natural fertility boosters may offer a holistic approach to enhancing fertility, but further research is necessary to fully elucidate its mechanisms and efficacy.
Disclaimer: This article is intended for informational purposes only and does not constitute medical advice. The effects of chaga mushroom on fertility and overall health are still being studied, and individual responses may vary. Before adding any herbal supplement to your routine, particularly when addressing fertility concerns, it is important to consult with a qualified healthcare professional. This information should not replace professional diagnosis or treatment.
FAQ
— Can chaga mushroom improve fertility naturally?
Chaga mushroom benefits for fertility are often discussed in traditional medicine, where it is believed to support overall reproductive health through its antioxidant properties. However, scientific evidence directly linking it to fertility improvement is limited and ongoing research is needed.
— Is chaga mushroom safe to use for fertility enhancement?
Chaga is generally considered safe when consumed in moderate amounts, but its safety specifically for fertility enhancement has not been extensively studied. Individuals with certain health conditions or those taking medications should consult a healthcare provider before use.
— What is the best way to consume chaga mushroom for fertility?
Chaga is typically consumed as a tea or extract, which allows for the release of its bioactive compounds. There is no standardized method specifically for fertility purposes, so traditional preparations are commonly used.
— Are there scientific studies supporting chaga mushroom benefits for fertility?
Research on chaga mushroom benefits for fertility is still in early stages, with most studies focusing on its antioxidant and immune-modulating effects rather than direct fertility outcomes. More rigorous clinical trials are necessary to establish clear links.
— How does chaga mushroom affect hormone levels?
Some compounds in chaga may influence hormone regulation indirectly by reducing oxidative stress and inflammation, but direct effects on hormone levels remain unclear. Scientific data on this topic is limited and often anecdotal.
— Can men benefit from chaga mushroom for fertility?
Men may potentially experience benefits due to chaga’s antioxidant properties, which could support sperm health and overall reproductive function. Nonetheless, definitive conclusions require further scientific validation.
— Are there any known side effects of chaga mushroom related to fertility?
There are no widely reported side effects of chaga that specifically impact fertility, but individual responses can vary. Caution is advised, especially for those with autoimmune conditions or on blood-thinning medications.
— How long does it take to see effects of chaga mushroom on fertility?
The timeline for any effects related to fertility is not well documented and may vary considerably between individuals. Given the lack of specific research, it is difficult to estimate how long any potential benefits might take to manifest.












